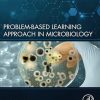

- 50 Patient Cases emphasize the biochemical concepts behind common patient symptoms through problem-based learning.
- Clinical Impression sections encourage critical thinking and train students step by step in building effective differential diagnoses.
- Basic Science Correlations in each Patient Case clarify the biochemical concepts underlying diagnosis with an engaging question-and-answer format.
- High-Yield Concepts summarized after each Patient Case reinforce students’ comprehension of essential chapter concepts.

Reviews
There are no reviews yet.